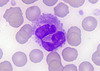

Blood Stuff Flashcards
(10 cards)
1
Q
Life Span & mm3 of RBC’s
A
120 days; 5.4 mil/mm3 (males) 4.8 mil/mm3 (females)
2
Q
Life Span & mm3 of WBC’s
A
Few hours/days; 5-10 thousand/mm3
3
Q
Life Span & mm3 of Platelets
A
5-9 days; 250-400 thousand mm/3
4
Q
What is this an image of? What percent of WBC’s?

A
Monocyte 3-8%
5
Q
What is this an image of? What percent of WBC’s?
A
Neutrophil 50-70%
6
Q
What is this an image of? What percent of WBC’s?

A
Lymphocyte 25%
7
Q
What is this an image of? What percent of WBC’s?
A
Eosoniphil
8
Q
What is this an image of? What percent of WBC’s?
A
Basophil 0.5-1%
9
Q
What percentage of solutes makes up plasma?
A
8.5%
10
Q
What percentage of water makes up plasma?
A
91.5%